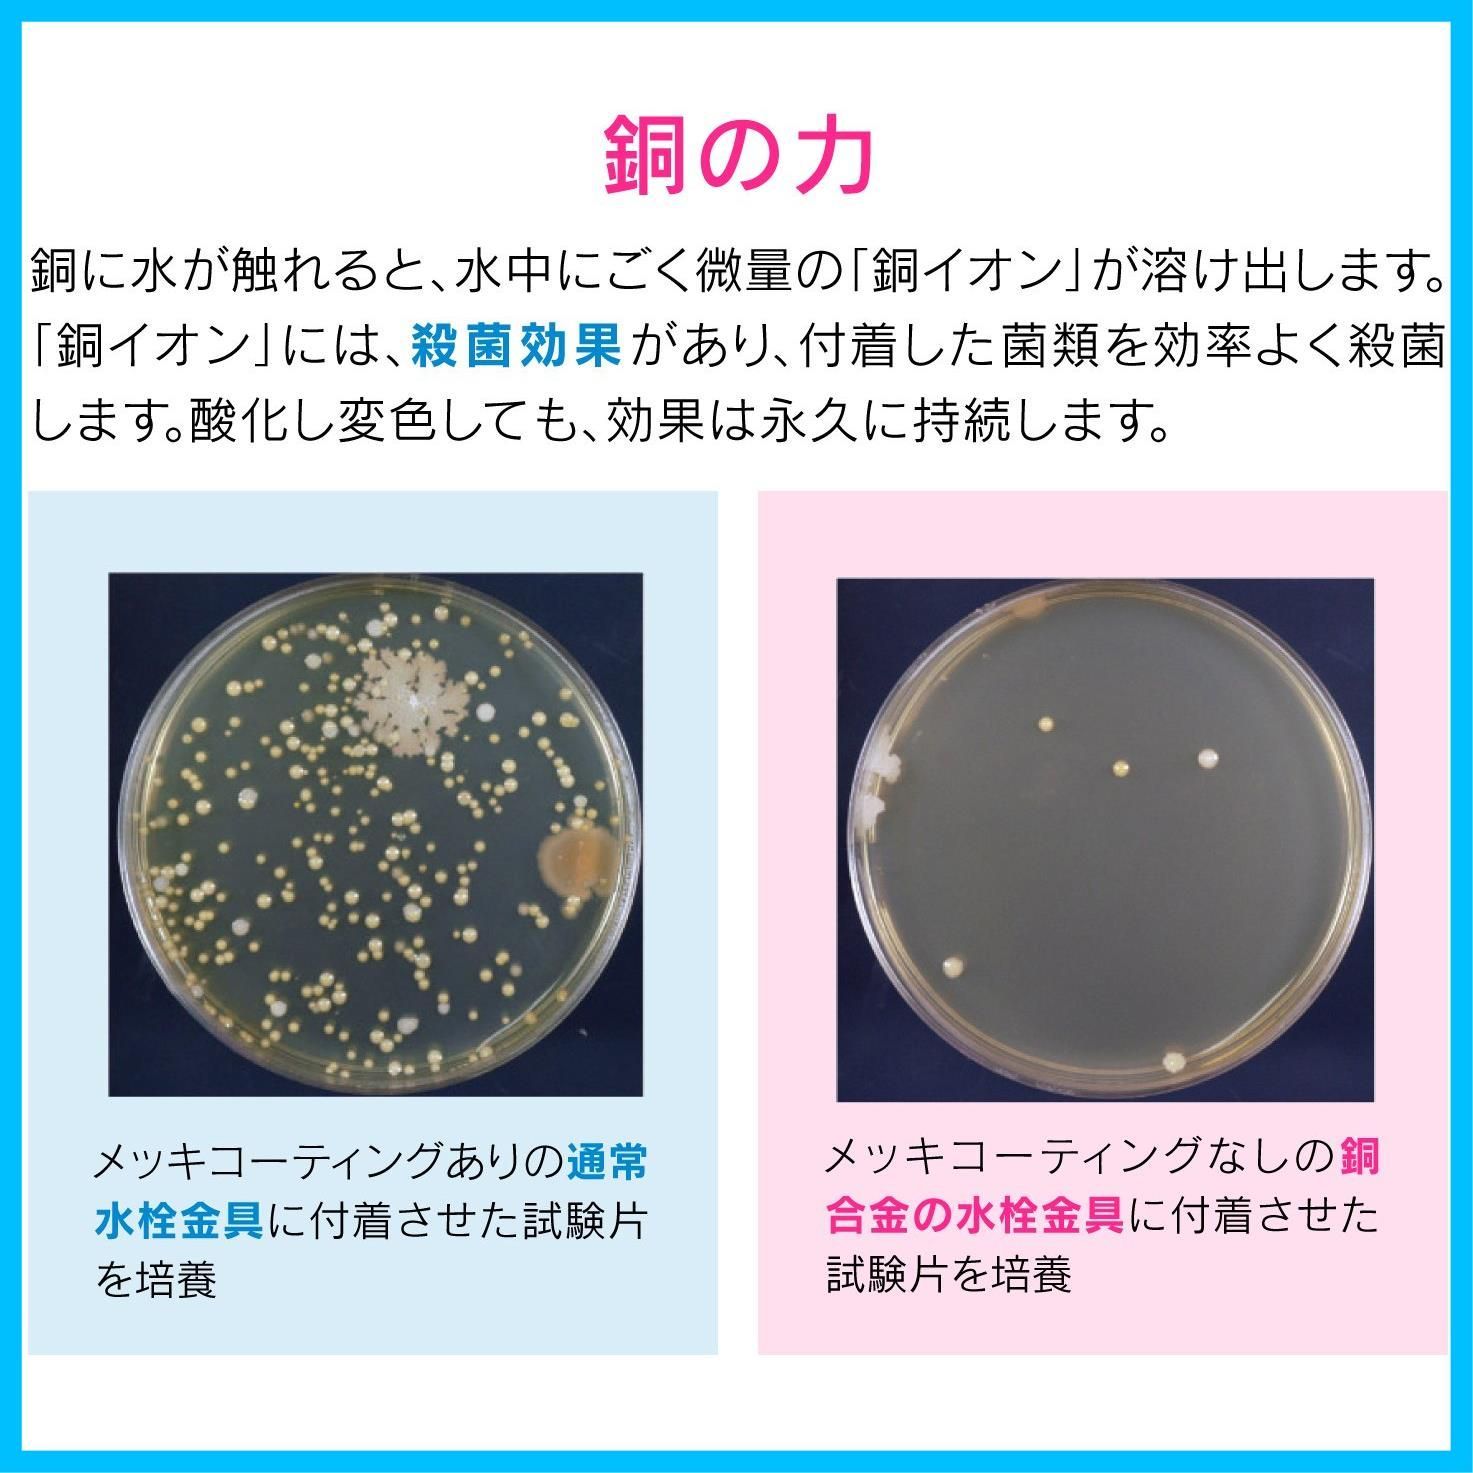

- www.aprilflower.org
- パーツレビュー
- タイヤ・ホイール
- タイヤ
- キッチン・日用品・その他
- 文房具・事務用品
- {{prodcut_title}}
商品 殺菌効果 銅製のゴミカゴとフタのセット ヌメリ 臭い防止 シンク用 衛生的 これカモ GA PB 028 ガオナ
商品 殺菌効果 銅製のゴミカゴとフタのセット ヌメリ 臭い防止 シンク用 衛生的 これカモ GA PB 028 ガオナ
4.7点
(51件)
レビュー一覧 51件 (総件数:51件)
おすすめの商品
Yahoo!ショッピングの商品を見る
[PR]
ご覧いただきありがとうございます。
当店では他サイトにも商品を販売しているため
まれに売り切れや取り寄せ中となる場合がありますがご了承ください。
ガオナ これカモ シンク用 銅製のゴミカゴとフタのセット 殺菌効果 (ヌメリ・臭い防止 衛生的) GA-PB028
ゴミカゴ直径:144ミリ×高さ:44.5ミリ、フタ直径:144ミリ×厚み:17ミリ
素材・材質:銅
生産国:日本
使用を重ねるうちに黒ずんでいき、しだいに薄青みがかった皮膜に変色しますが、銅イオンの殺菌効果は変わりません。
キッチンのシンク用の排水口フタと浅型ゴミカゴのセット(直径145ミリ用)です。
キッチンのシンク用の排水プレートと浅型ゴミカゴのセット。
銅イオンの殺菌効果でヌメリやにおいを防止。
排水プレートは、排水カゴのゴミを隠して見た目すっきり。
浅型ゴミカゴには取っ手が付いているので、取外しが簡単。
浅型バスケットなので、こまめなゴミ捨てでいつも清潔。
最後までご確認頂き誠にありがとうございました。
上記をご確認頂き、ご購入いただけましたら幸いです。
何かご不明な点がございましたらお気軽にメッセージからお問い合わせ下さい。
当店では他サイトにも商品を販売しているため
まれに売り切れや取り寄せ中となる場合がありますがご了承ください。
ガオナ これカモ シンク用 銅製のゴミカゴとフタのセット 殺菌効果 (ヌメリ・臭い防止 衛生的) GA-PB028
ゴミカゴ直径:144ミリ×高さ:44.5ミリ、フタ直径:144ミリ×厚み:17ミリ
素材・材質:銅
生産国:日本
使用を重ねるうちに黒ずんでいき、しだいに薄青みがかった皮膜に変色しますが、銅イオンの殺菌効果は変わりません。
キッチンのシンク用の排水口フタと浅型ゴミカゴのセット(直径145ミリ用)です。
キッチンのシンク用の排水プレートと浅型ゴミカゴのセット。
銅イオンの殺菌効果でヌメリやにおいを防止。
排水プレートは、排水カゴのゴミを隠して見た目すっきり。
浅型ゴミカゴには取っ手が付いているので、取外しが簡単。
浅型バスケットなので、こまめなゴミ捨てでいつも清潔。
最後までご確認頂き誠にありがとうございました。
上記をご確認頂き、ご購入いただけましたら幸いです。
何かご不明な点がございましたらお気軽にメッセージからお問い合わせ下さい。
カテゴリー:
キッチン・日用品・その他##文房具・事務用品##その他
商品の状態:
新品、未使用
配送料の負担:
送料無料
配送の方法:
未定(出品者が手配)
発送元の地域:
東京都
発送までの日数:
2~5日
マイページでカーライフを便利に楽しく!!
イベント・キャンペーン
-
8000 円
-
30000 円